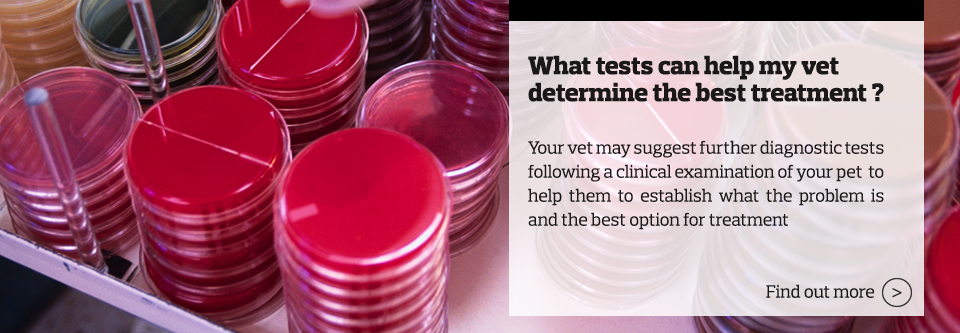

<
>

Welcome to It’s Infectious
At Vétoquinol, we believe that antibiotics should be used only when necessary and given according to the appropriate guidelines. Appropriate antibiotic use and infection control are key issues facing the population today and we are doing our utmost to support the responsible use of our products and to therefore help prevent antibiotic resistance. This includes the education of veterinary practice staff and pet owners, along with working with some key individuals and organisations to support a global perspective on this important topic.
About Vétoquinol
Vétoquinol is a family owned, independent company dedicated to improving animal health. Encompassing research and development, manufacturing, marketing and sales, veterinarians have benefited from the company’s expertise in the fields of anti-infectives, anti-inflammatories, anti-parasitics and complementary feeds for animals.
Disclaimer: This website has been designed to offer information surrounding the use of antibiotics and infection control for pet owners. It does not replace advice from your veterinary surgeon. If you believe your pet is unwell or you have any questions relating to their treatment, please always contact your veterinary surgeon for advice.



